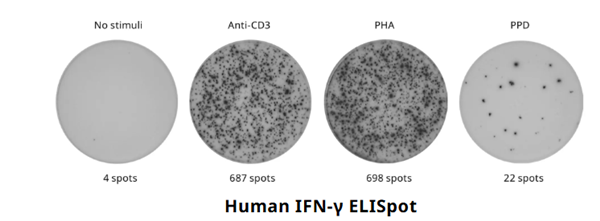
ELISpot-2.png

PRODUCT CENTER
特色產(chǎn)品當(dāng)前位置:首頁 > 特色產(chǎn)品
ELISpot是一種強(qiáng)大且簡便的工具,能夠在單細(xì)胞水平上檢測和定量抗原特異性免疫反應(yīng)。近 40 年來,研究人員一直信賴 Mabtech 的 ELISpot 試劑盒,因其在捕獲 T 細(xì)胞和 B 細(xì)胞反應(yīng)方面具有可靠的性能和高靈敏度。那么,ELISpot 是如何工作的呢?該檢測的原理類似于ELISA,但與其在溶液中檢測分析物不同,它檢測的是分泌該分析物的細(xì)胞。免疫細(xì)胞在預(yù)先包被有針對感興趣分析物的特異性捕獲抗體的孔中被激活。反應(yīng)細(xì)胞分泌分析物,這些分析物立即被板上的抗體捕獲。孵育后,細(xì)胞被洗去,加入檢測抗體,隨后加入顯色試劑以顯示斑點。每個斑點代表一個單獨的反應(yīng)細(xì)胞,提供了免疫活性的精確且可定量的檢測方式。

ELISA和ELISpot有什么區(qū)別?雖然兩者都是靈敏的夾心法檢測,但ELISA檢測的是溶液(如血漿或血清)中的分析物濃度,而ELISpot則直接從細(xì)胞分泌時檢測分析物。ELISA提供分析物濃度,而ELISpot 則定量分泌細(xì)胞的數(shù)量(斑點形成單位,SFU)以及它們的分泌水平(相對斑點體積,RSV)。這使得ELISpot特別靈敏,因為它在整個細(xì)胞刺激過程中持續(xù)捕獲分析物。此外,由于ELISpot在分泌后立即捕獲目標(biāo)蛋白,該方法可以檢測到那些在其他情況下因稀釋或從樣本中消失而難以檢測到的細(xì)胞因子。例如,ELISpot可以檢測到被蛋白酶快速降解的分析物(如 IL-2)、被旁觀者細(xì)胞迅速吸收的分析物(如IL-4)或與可溶性受體結(jié)合的分析物(如 TNF-α)。

Mabtech的ELISpot試劑盒因其在單細(xì)胞水平上檢測抗原特異性免疫反應(yīng)的穩(wěn)健性和卓越靈敏度,贏得了臨床試驗實驗室、制藥公司和CRO的信任。作為評估抗原特異性T細(xì)胞和B細(xì)胞的“金標(biāo)準(zhǔn)”,ELISpot非常適合在臨床前研究和臨床試驗中全程跟蹤免疫反應(yīng)。無論您是在評估疫苗的有效性、評估免疫調(diào)節(jié)效果,還是監(jiān)測細(xì)胞療法的效力,Mabtech的ELISpot試劑盒都能無縫整合到免疫監(jiān)測工作流程中,提供推動治療成功所必需的高質(zhì)量、可靠數(shù)據(jù)。
T細(xì)胞表型分析
ELISpot常用于研究抗原特異性免疫反應(yīng),并區(qū)分激活的T細(xì)胞亞群。它廣泛應(yīng)用于傳染病、癌癥、過敏癥和自身免疫疾病的研究中。在疫苗研究中,ELISpot是衡量疫苗效力的“金標(biāo)準(zhǔn)”,通過測量疫苗誘導(dǎo)T細(xì)胞反應(yīng)的能力,例如通過檢測干擾素-γ(IFN-γ)的分泌來評估。
B細(xì)胞表型分析
B細(xì)胞ELISpot檢測是少數(shù)幾種能夠直接檢測分泌后的免疫球蛋白的檢測方法之一。它有兩種策略:首先,B細(xì)胞ELISpot可用于評估抗體分泌細(xì)胞(ASCs)。由于其靈敏度,該方法能夠識別針對特定抗原的稀有抗體分泌細(xì)胞。其次,您可以在多克隆激活后評估循環(huán)中的抗原特異性記憶B細(xì)胞。因此,B細(xì)胞ELISpot常用于檢測由感染或疫苗接種誘導(dǎo)的B細(xì)胞反應(yīng)。

Mabtech可以提供多種不同規(guī)格和檢測試劑的ELISpot產(chǎn)品。從超級靈活的到即用型試劑盒,都能滿足您的需求。盡管Mabtech更傾向于使用 ALP(堿性磷酸酶)檢測系統(tǒng),但Mabtech同樣提供帶有HRP(辣根過氧化物酶)檢測試劑的試劑盒。
 |  |  |  |
| ELISpot Flex版本 | ELISpot Plus版本 | ELISpot Pro版本 | ELISpot Path版本 |
| 基礎(chǔ)款(沒有板子和底物,省錢) | 即用型試劑盒(最推薦) | 一步法即用型試劑盒(省時間) | 即用型試劑盒,包含肽池和陽性對照 |
 | |||
| 貨號 | 名稱 | 用途 |
| 3012-4APW-2 | ELISpotPlus:牛TNF-α(ALP) | 該ELISpot試劑盒用于通過ELISpot檢測方法技術(shù)分泌牛TNF-α的細(xì)胞 |
| 3012-4HPW-2 | ELISpotPlus:牛TNF-α(HRP) | 該ELISpot試劑盒用于通過ELISpot檢測方法技術(shù)分泌牛TNF-α的細(xì)胞 |
| 3020-4APW-2 | ELISpotPlus:豬IL-17A(ALP) | 該ELISpot試劑盒用于通過ELISpot檢測方法技術(shù)分泌豬IL-17A的細(xì)胞 |
| 3020-4HPW-2 | ELISpotPlus:豬IL-17A(HRP) | 該ELISpot試劑盒用于通過ELISpot檢測方法技術(shù)分泌豬IL-17A的細(xì)胞 |
| 3102-4APW-2 | ELISpotPlus:倉鼠IFN-γ(ALP) | 該ELISpot試劑盒用于通過ELISpot檢測方法技術(shù)分泌倉鼠IFN-γ的細(xì)胞 |
| 3102-4HPW-2 | ELISpotPlus:倉鼠IFN-γ(HRP) | 該ELISpot試劑盒用于通過ELISpot檢測方法技術(shù)分泌倉鼠IFN-γ的細(xì)胞 |
| 3109-4APW-2 | ELISpotPlus:牛IL-17A(ALP) | 該ELISpot試劑盒用于通過ELISpot檢測方法技術(shù)分泌牛IL-17A的細(xì)胞 |
| 3109-4HPW-2 | ELISpotPlus:牛IL-17A(HRP) | 該ELISpot試劑盒用于通過ELISpot檢測方法技術(shù)分泌牛IL-17A的細(xì)胞 |
| 3110-4APW-2 | ELISpotPlus:兔IFN-γ(ALP) | 該ELISpot試劑盒用于通過ELISpot檢測方法技術(shù)分泌兔IFN-γ的細(xì)胞 |
| 3110-4HPW-2 | ELISpotPlus:兔IFN-γ(HRP) | 該ELISpot試劑盒用于通過ELISpot檢測方法技術(shù)分泌兔IFN-γ的細(xì)胞 |
| 3111-4APW-2 | ELISpotPlus:牛IL-2(ALP) | 該ELISpot試劑盒用于通過ELISpot檢測方法技術(shù)分泌牛IL-2的細(xì)胞 |
| 3111-4HPW-2 | ELISpotPlus:牛IL-2(HRP) | 該ELISpot試劑盒用于通過ELISpot檢測方法技術(shù)分泌牛IL-2的細(xì)胞 |
| 3114-4APW-2 | ELISpotPlus:牛IL-8(ALP) | 該ELISpot試劑盒用于通過ELISpot檢測方法技術(shù)分泌牛IL-8(CXCL8)的細(xì)胞 |
| 3114-4HPW-2 | ELISpotPlus:牛IL-8(HRP) | 該ELISpot試劑盒用于通過ELISpot檢測方法技術(shù)分泌牛IL-8(CXCL8)的細(xì)胞 |
| 3118-4APW-2 | ELISpotPlus:牛IL-4(ALP) | 該ELISpot試劑盒用于通過ELISpot檢測方法技術(shù)分泌牛IL-4的細(xì)胞 |
| 3118-4HPW-2 | ELISpotPlus:牛IL-4(HRP) | 該ELISpot試劑盒用于通過ELISpot檢測方法技術(shù)分泌牛IL-4的細(xì)胞 |
| 3119-4APW-2 | ELISpotPlus:牛IFN-γ(ALP) | 該ELISpot試劑盒用于通過ELISpot檢測方法技術(shù)分泌牛IFN-γ的細(xì)胞 |
| 3119-4HPW-2 | ELISpotPlus:牛IFN-γ(HRP) | 該ELISpot試劑盒用于通過ELISpot檢測方法技術(shù)分泌牛IFN-γ的細(xì)胞 |
| 3125-4APW-2 | ELISpotPlus:雞IFN-γ(ALP) | 該ELISpot試劑盒用于通過ELISpot檢測方法技術(shù)分泌雞IFN-γ的細(xì)胞 |
| 3125-4HPW-2 | ELISpotPlus:雞IFN-γ(HRP) | 該ELISpot試劑盒用于通過ELISpot檢測方法技術(shù)分泌雞IFN-γ的細(xì)胞 |
| 3127-4APW-2 | ELISpotPlus:羊IL-17A(ALP) | 該ELISpot試劑盒用于通過ELISpot檢測方法技術(shù)分泌羊IL-17A的細(xì)胞 |
| 3127-4HPW-2 | ELISpotPlus:羊IL-17A(HRP) | 該ELISpot試劑盒用于通過ELISpot檢測方法技術(shù)分泌羊IL-17A的細(xì)胞 |
| 3130-4APW-2 | ELISpotPlus:豬IFN-γ(ALP) | 該ELISpot試劑盒用于通過ELISpot檢測方法技術(shù)分泌豬IFN-γ的細(xì)胞 |
| 3130-4HPW-2 | ELISpotPlus:豬IFN-γ(HRP) | 該ELISpot試劑盒用于通過ELISpot檢測方法技術(shù)分泌豬IFN-γ的細(xì)胞 |
| 3135-4APW-2 | ELISpotPlus:豬TNF-α(ALP) | 該ELISpot試劑盒用于通過ELISpot檢測方法技術(shù)分泌豬TNF-α的細(xì)胞 |
| 3135-4HPW-2 | ELISpotPlus:豬TNF-α(HRP) | 該ELISpot試劑盒用于通過ELISpot檢測方法技術(shù)分泌豬TNF-α的細(xì)胞 |
| 3139-4APW-2 | ELISpotPlus:山羊IL-17A(ALP) | 該ELISpot試劑盒用于通過ELISpot檢測方法技術(shù)分泌山羊IL-17A的細(xì)胞 |
| 3139-4HPW-2 | ELISpotPlus:山羊IL-17A(HRP) | 該ELISpot試劑盒用于通過ELISpot檢測方法技術(shù)分泌山羊IL-17A的細(xì)胞 |
| 3140-4APW-2 | ELISpotPlus:豬IL-2(ALP) | 該ELISpot試劑盒用于通過ELISpot檢測方法技術(shù)分泌豬IL-2的細(xì)胞 |
| 3140-4HPW-2 | ELISpotPlus:豬IL-2(HRP) | 該ELISpot試劑盒用于通過ELISpot檢測方法技術(shù)分泌豬IL-2的細(xì)胞 |
| 3194-4APW-2 | ELISpotPlus:豬IL-5(ALP) | 該ELISpot試劑盒用于通過ELISpot檢測方法技術(shù)分泌豬IL-5的細(xì)胞 |
| 3221-4APW-2 | ELISpotPlus:大鼠IFN-γ(ALP) | 該ELISpot試劑盒用于通過ELISpot檢測方法技術(shù)分泌大鼠IFN-γ的細(xì)胞 |
| 3221-4HPW-2 | ELISpotPlus:大鼠IFN-γ(HRP) | 該ELISpot試劑盒用于通過ELISpot檢測方法技術(shù)分泌大鼠IFN-γ的細(xì)胞 |
| 3275-4APW-2 | ELISpotPlus:大鼠IL-22(ALP) | 該ELISpot試劑盒用于通過ELISpot檢測方法技術(shù)分泌大鼠IL-22的細(xì)胞 |
| 3275-4HPW-2 | ELISpotPlus:大鼠IL-22(HRP) | 該ELISpot試劑盒用于通過ELISpot檢測方法技術(shù)分泌大鼠IL-22的細(xì)胞 |
| 3311-4APW-2 | ELISpotPlus:小鼠IL-4(ALP) | 該ELISpot試劑盒用于通過ELISpot檢測方法技術(shù)分泌小鼠IL-4的細(xì)胞 |
| 3311-4HPW-2 | ELISpotPlus:小鼠IL-4(HRP) | 該ELISpot試劑盒用于通過ELISpot檢測方法技術(shù)分泌小鼠IL-4的細(xì)胞 |
| 3317-4APW-2 | ELISpotPlus:小鼠IL-1β(ALP) | 該ELISpot試劑盒用于通過ELISpot檢測方法技術(shù)分泌小鼠IL-1β的細(xì)胞 |
| 3317-4HPW-2 | ELISpotPlus:小鼠IL-1β(HRP) | 該ELISpot試劑盒用于通過ELISpot檢測方法技術(shù)分泌小鼠IL-1β的細(xì)胞 |
| 3321-4APT-2 | ELISpotPlus:小鼠IFN-γ(ALP) | 該ELISpot試劑盒用于通過ELISpot檢測方法技術(shù)分泌小鼠IFN-γ的細(xì)胞 |
| 3321-4APW-2 | ELISpotPlus:小鼠IFN-γ(ALP) | 該ELISpot試劑盒用于通過ELISpot檢測方法技術(shù)分泌小鼠IFN-γ的細(xì)胞 |
| 3321-4AST-2 | ELISpotPlus:小鼠IFN-γ(ALP) | 該ELISpot試劑盒用于通過ELISpot檢測方法技術(shù)分泌小鼠IFN-γ的細(xì)胞 |
| 3321-4HPT-2 | ELISpotPlus:小鼠IFN-γ(HRP) | 該ELISpot試劑盒用于通過ELISpot檢測方法技術(shù)分泌小鼠IFN-γ的細(xì)胞 |
| 3321-4HPW-2 | ELISpotPlus:小鼠IFN-γ(HRP) | 該ELISpot試劑盒用于通過ELISpot檢測方法技術(shù)分泌小鼠IFN-γ的細(xì)胞 |
| 3321-4HST-2 | ELISpotPlus:小鼠IFN-γ(HRP) | 該ELISpot試劑盒用于通過ELISpot檢測方法技術(shù)分泌小鼠IFN-γ的細(xì)胞 |
| 3376-4APW-2 | ELISpotPlus:小鼠IL-22(ALP) | 該ELISpot試劑盒用于通過ELISpot檢測方法技術(shù)分泌小鼠IL-22的細(xì)胞 |
| 3376-4HPW-2 | ELISpotPlus:小鼠IL-22(HRP) | 該ELISpot試劑盒用于通過ELISpot檢測方法技術(shù)分泌小鼠IL-22的細(xì)胞 |
| 3391-4APW-2 | ELISpotPlus:小鼠IL-5(ALP) | 該ELISpot試劑盒用于通過ELISpot檢測方法技術(shù)分泌小鼠IL-5的細(xì)胞 |
| 3391-4HPW-2 | ELISpotPlus:小鼠IL-5(HRP) | 該ELISpot試劑盒用于通過ELISpot檢測方法技術(shù)分泌小鼠IL-5的細(xì)胞 |
| 3401-4APW-2 | ELISpotPlus:人IP-10(ALP) | 該ELISpot試劑盒用于通過ELISpot檢測方法技術(shù)分泌人IP-10的細(xì)胞 |
| 3401-4HPW-2 | ELISpotPlus:人IP-10(HRP) | 該ELISpot試劑盒用于通過ELISpot檢測方法技術(shù)分泌人IP-10的細(xì)胞 |
| 3401M-4APW-2 | ELISpotPlus:猴IP-10(ALP) | 該ELISpot試劑盒用于通過ELISpot檢測方法技術(shù)分泌猴IP-10的細(xì)胞 |
| 3401M-4HPW-2 | ELISpotPlus:猴IP-10(HRP) | 該ELISpot試劑盒用于通過ELISpot檢測方法技術(shù)分泌猴IP-10的細(xì)胞 |
| 3410-4APW-2 | ELISpotPlus:人IL-4(ALP) | 該ELISpot試劑盒用于通過ELISpot檢測方法技術(shù)分泌人IL-4的細(xì)胞 |
| 3410-4HPW-2 | ELISpotPlus:人IL-4(HRP) | 該ELISpot試劑盒用于通過ELISpot檢測方法技術(shù)分泌人IL-4的細(xì)胞 |
| 3414-4APW-2 | ELISpotPlus:人IL-1α(ALP) | 該ELISpot試劑盒用于通過ELISpot檢測方法技術(shù)分泌人IL-1α的細(xì)胞 |
| 3414-4HPW-2 | ELISpotPlus:人IL-1α(HRP) | 該ELISpot試劑盒用于通過ELISpot檢測方法技術(shù)分泌人IL-1α的細(xì)胞 |
| 3416-4APW-2 | ELISpotPlus:人IL-1β(ALP) | 該ELISpot試劑盒用于通過ELISpot檢測方法技術(shù)分泌人IL-1β的細(xì)胞 |
| 3416-4HPW-2 | ELISpotPlus:人IL-1β(HRP) | 該ELISpot試劑盒用于通過ELISpot檢測方法技術(shù)分泌人IL-1β的細(xì)胞 |
| 3417-4APW-2 | ELISpotPlus:小鼠IL-1α(ALP) | 該ELISpot試劑盒用于通過ELISpot檢測方法技術(shù)分泌小鼠IL-1α的細(xì)胞 |
| 3417-4HPW-2 | ELISpotPlus:小鼠IL-1α(HRP) | 該ELISpot試劑盒用于通過ELISpot檢測方法技術(shù)分泌小鼠IL-1α的細(xì)胞 |
| 3420-4APT-2 | ELISpotPlus:人IFN-γ(ALP) | 該ELISpot試劑盒用于通過ELISpot檢測方法技術(shù)分泌人IFN-γ的細(xì)胞 |
| 3420-4APW-2 | ELISpotPlus:人IFN-γ(ALP) | 該ELISpot試劑盒用于通過ELISpot檢測方法技術(shù)分泌人IFN-γ的細(xì)胞 |
| 3420-4AST-2 | ELISpotPlus:人IFN-γ(ALP) | 該ELISpot試劑盒用于通過ELISpot檢測方法技術(shù)分泌人IFN-γ的細(xì)胞 |
| 3420-4HPT-2 | ELISpotPlus:人IFN-γ(HRP) | 該ELISpot試劑盒用于通過ELISpot檢測方法技術(shù)分泌人IFN-γ的細(xì)胞 |
| 3420-4HPW-2 | ELISpotPlus:人IFN-γ(HRP) | 該ELISpot試劑盒用于通過ELISpot檢測方法技術(shù)分泌人IFN-γ的細(xì)胞 |
| 3420-4HST-2 | ELISpotPlus:人IFN-γ(HRP) | 該ELISpot試劑盒用于通過ELISpot檢測方法技術(shù)分泌人IFN-γ的細(xì)胞 |
| 3421M-4APT-2 | ELISpotPlus:猴IFN-γ(ALP) | 該ELISpot試劑盒用于通過ELISpot檢測方法技術(shù)分泌猴IFN-γ的細(xì)胞 |
| 3421M-4APW-2 | ELISpotPlus:猴IFN-γ(ALP) | 該ELISpot試劑盒用于通過ELISpot檢測方法技術(shù)分泌猴IFN-γ的細(xì)胞 |
| 3421M-4AST-2 | ELISpotPlus:猴IFN-γ(ALP) | 該ELISpot試劑盒用于通過ELISpot檢測方法技術(shù)分泌猴IFN-γ的細(xì)胞 |
| 3421M-4HPT-2 | ELISpotPlus:猴IFN-γ(HRP) | 該ELISpot試劑盒用于通過ELISpot檢測方法技術(shù)分泌猴IFN-γ的細(xì)胞 |
| 3421M-4HPW-2 | ELISpotPlus:猴IFN-γ(HRP) | 該ELISpot試劑盒用于通過ELISpot檢測方法技術(shù)分泌猴IFN-γ的細(xì)胞 |
| 3421M-4HST-2 | ELISpotPlus:猴IFN-γ(HRP) | 該ELISpot試劑盒用于通過ELISpot檢測方法技術(shù)分泌猴IFN-γ的細(xì)胞 |
| 3425-4APW-2 | ELISpotPlus:人IFN-α(ALP) | 該ELISpot試劑盒用于通過ELISpot檢測方法技術(shù)分泌人IFN-α的細(xì)胞 |
| 3425-4HPW-2 | ELISpotPlus:人IFN-α(HRP) | 該ELISpot試劑盒用于通過ELISpot檢測方法技術(shù)分泌人IFN-α的細(xì)胞 |
| 3430-4APW-2 | ELISpotPlus:人IL-10(ALP) | 該ELISpot試劑盒用于通過ELISpot檢測方法技術(shù)分泌人IL-10的細(xì)胞 |
| 3430-4HPW-2 | ELISpotPlus:人IL-10(HRP) | 該ELISpot試劑盒用于通過ELISpot檢測方法技術(shù)分泌人IL-10的細(xì)胞 |
| 3430M-4APW-2 | ELISpotPlus:猴IL-10(ALP) | 該ELISpot試劑盒用于通過ELISpot檢測方法技術(shù)分泌猴IL-10的細(xì)胞 |
| 3430M-4HPW-2 | ELISpotPlus:猴IL-10(HRP) | 該ELISpot試劑盒用于通過ELISpot檢測方法技術(shù)分泌猴IL-10的細(xì)胞 |
| 3432-4APW-2 | ELISpotPlus:小鼠IL-10(ALP) | 該ELISpot試劑盒用于通過ELISpot檢測方法技術(shù)分泌小鼠IL-10的細(xì)胞 |
| 3432-4HPW-2 | ELISpotPlus:小鼠IL-10(HRP) | 該ELISpot試劑盒用于通過ELISpot檢測方法技術(shù)分泌小鼠IL-10的細(xì)胞 |
| 3435-4APW-2 | ELISpotPlus:人IL-3(ALP) | 該ELISpot試劑盒用于通過ELISpot檢測方法技術(shù)分泌人IL-3的細(xì)胞 |
| 3435-4HPW-2 | ELISpotPlus:人IL-3(HRP) | 該ELISpot試劑盒用于通過ELISpot檢測方法技術(shù)分泌人IL-3的細(xì)胞 |
| 3441-4APW-2 | ELISpotPlus:小鼠IL-2(ALP) | 該ELISpot試劑盒用于通過ELISpot檢測方法技術(shù)分泌小鼠IL-2的細(xì)胞 |
| 3441-4HPW-2 | ELISpotPlus:小鼠IL-2(HRP) | 該ELISpot試劑盒用于通過ELISpot檢測方法技術(shù)分泌小鼠IL-2的細(xì)胞 |
| 3445-4APW-2 | ELISpotPlus:人IL-2(ALP) | 該ELISpot試劑盒用于通過ELISpot檢測方法技術(shù)分泌人IL-2的細(xì)胞 |
| 3445-4HPW-2 | ELISpotPlus:人IL-2(HRP) | 該ELISpot試劑盒用于通過ELISpot檢測方法技術(shù)分泌人IL-2的細(xì)胞 |
| 3445M-4APW-2 | ELISpotPlus:猴IL-2(ALP) | 該ELISpot試劑盒用于通過ELISpot檢測方法技術(shù)分泌猴IL-2的細(xì)胞 |
| 3445M-4HPW-2 | ELISpotPlus:猴IL-2(HRP) | 該ELISpot試劑盒用于通過ELISpot檢測方法技術(shù)分泌猴IL-2的細(xì)胞 |
| 3450-4APW-2 | ELISpotPlus:人IL-12/-23p40(ALP) | 該ELISpot試劑盒用于通過ELISpot檢測方法技術(shù)分泌人IL-12/-23p40的細(xì)胞 |
| 3450-4HPW-2 | ELISpotPlus:人IL-12/-23p40(HRP) | 該ELISpot試劑盒用于通過ELISpot檢測方法技術(shù)分泌人IL-12/-23p40的細(xì)胞 |
| 3451-4APW-2 | ELISpotPlus:小鼠IL-12/-23p40(ALP) | 該ELISpot試劑盒用于通過ELISpot檢測方法技術(shù)分泌小鼠IL-12/-23p40的細(xì)胞 |
| 3451-4HPW-2 | ELISpotPlus:小鼠IL-12/-23p40(HRP) | 該ELISpot試劑盒用于通過ELISpot檢測方法技術(shù)分泌小鼠IL-12/-23p40的細(xì)胞 |
| 3455-4APW-2 | ELISpotPlus:人IL-12p70(ALP) | 該ELISpot試劑盒用于通過ELISpot檢測方法技術(shù)分泌人IL-12p70的細(xì)胞 |
| 3455-4HPW-2 | ELISpotPlus:人IL-12p70(HRP) | 該ELISpot試劑盒用于通過ELISpot檢測方法技術(shù)分泌人IL-12p70的細(xì)胞 |
| 3456-4APW-2 | ELISpotPlus:小鼠IL-12p70(ALP) | 該ELISpot試劑盒用于通過ELISpot檢測方法技術(shù)分泌小鼠IL-12p70的細(xì)胞 |
| 3456-4HPW-2 | ELISpotPlus:小鼠IL-12p70(HRP) | 該ELISpot試劑盒用于通過ELISpot檢測方法技術(shù)分泌小鼠IL-12p70的細(xì)胞 |
| 3457-4APW-2 | ELISpotPlus:人IL-23(ALP) | 該ELISpot試劑盒用于通過ELISpot檢測方法技術(shù)分泌人IL-23的細(xì)胞 |
| 3457-4HPW-2 | ELISpotPlus:人IL-23(HRP) | 該ELISpot試劑盒用于通過ELISpot檢測方法技術(shù)分泌人IL-23的細(xì)胞 |
| 3458-4APW-2 | ELISpotPlus:人IL-27(ALP) | 該ELISpot試劑盒用于通過ELISpot檢測方法技術(shù)分泌人IL-27的細(xì)胞 |
| 3458-4HPW-2 | ELISpotPlus:人IL-27(HRP) | 該ELISpot試劑盒用于通過ELISpot檢測方法技術(shù)分泌人IL-27的細(xì)胞 |
| 3459-4APW-2 | ELISpotPlus:人EBI3(ALP) | 該ELISpot試劑盒用于通過ELISpot檢測方法技術(shù)分泌人EBI3的細(xì)胞 |
| 3459-4HPW-2 | ELISpotPlus:人EBI3(HRP) | 該ELISpot試劑盒用于通過ELISpot檢測方法技術(shù)分泌人EBI3的細(xì)胞 |
| 3465-4APW-2 | ELISpotPlus:人穿孔素(ALP) | 該ELISpot試劑盒用于通過ELISpot檢測方法技術(shù)分泌人穿孔素的細(xì)胞 |
| 3465-4HPW-2 | ELISpotPlus:人穿孔素(HRP) | 該ELISpot試劑盒用于通過ELISpot檢測方法技術(shù)分泌人穿孔素的細(xì)胞 |
| 3470M-4APW-2 | ELISpotPlus:猴IL-13(ALP) | 該ELISpot試劑盒用于通過ELISpot檢測方法技術(shù)分泌猴IL-13的細(xì)胞 |
| 3470M-4HPW-2 | ELISpotPlus:猴IL-13(HRP) | 該ELISpot試劑盒用于通過ELISpot檢測方法技術(shù)分泌猴IL-13的細(xì)胞 |
| 3471-4APW-2 | ELISpotPlus:人IL-13(ALP) | 該ELISpot試劑盒用于通過ELISpot檢測方法技術(shù)分泌人IL-13的細(xì)胞 |
| 3471-4HPW-2 | ELISpotPlus:人IL-13(HRP) | 該ELISpot試劑盒用于通過ELISpot檢測方法技術(shù)分泌人IL-13的細(xì)胞 |
| 3475-4APW-2 | ELISpotPlus:人IL-22(ALP) | 該ELISpot試劑盒用于通過ELISpot檢測方法技術(shù)分泌人IL-22的細(xì)胞 |
| 3475-4HPW-2 | ELISpotPlus:人IL-22(HRP) | 該ELISpot試劑盒用于通過ELISpot檢測方法技術(shù)分泌人IL-22的細(xì)胞 |
| 3480-4APW-2 | ELISpotPlus:人GM-CSF(ALP) | 該ELISpot試劑盒用于通過ELISpot檢測方法技術(shù)分泌人GM-CSF的細(xì)胞 |
| 3480-4HPW-2 | ELISpotPlus:人GM-CSF(HRP) | 該ELISpot試劑盒用于通過ELISpot檢測方法技術(shù)分泌人GM-CSF的細(xì)胞 |
| 3486-4APW-2 | ELISpotPlus:人顆粒酶B(ALP) | 該ELISpot試劑盒用于通過ELISpot檢測方法技術(shù)分泌人顆粒酶B的細(xì)胞 |
| 3486-4HPW-2 | ELISpotPlus:人顆粒酶B(HRP) | 該ELISpot試劑盒用于通過ELISpot檢測方法技術(shù)分泌人顆粒酶B的細(xì)胞 |
| 3486M-4APW-2 | ELISpotPlus:猴顆粒酶B(ALP) | 該ELISpot試劑盒用于通過ELISpot檢測方法技術(shù)分泌猴顆粒酶B的細(xì)胞 |
| 3486M-4HPW-2 | ELISpotPlus:猴顆粒酶B(HRP) | 該ELISpot試劑盒用于通過ELISpot檢測方法技術(shù)分泌猴顆粒酶B的細(xì)胞 |
| 3490-4APW-2 | ELISpotPlus:人IL-5(ALP) | 該ELISpot試劑盒用于通過ELISpot檢測方法技術(shù)分泌人IL-5的細(xì)胞 |
| 3490-4HPW-2 | ELISpotPlus:人IL-5(HRP) | 該ELISpot試劑盒用于通過ELISpot檢測方法技術(shù)分泌人IL-5的細(xì)胞 |
| 3511-4APW-2 | ELISpotPlus:小鼠TNF-α(ALP) | 該ELISpot試劑盒用于通過ELISpot檢測方法技術(shù)分泌小鼠TNF-α的細(xì)胞 |
| 3511-4HPW-2 | ELISpotPlus:小鼠TNF-α(HRP) | 該ELISpot試劑盒用于通過ELISpot檢測方法技術(shù)分泌小鼠TNF-α的細(xì)胞 |
| 3512-4APW-2 | ELISpotPlus:人TNF-α(ALP) | 該ELISpot試劑盒用于通過ELISpot檢測方法技術(shù)分泌人TNF-α的細(xì)胞 |
| 3512-4HPW-2 | ELISpotPlus:人TNF-α(HRP) | 該ELISpot試劑盒用于通過ELISpot檢測方法技術(shù)分泌人TNF-α的細(xì)胞 |
| 3512M-4APW-2 | ELISpotPlus:猴TNF-α(ALP) | 該ELISpot試劑盒用于通過ELISpot檢測方法技術(shù)分泌猴TNF-α的細(xì)胞 |
| 3512M-4HPW-2 | ELISpotPlus:猴TNF-α(HRP) | 該ELISpot試劑盒用于通過ELISpot檢測方法技術(shù)分泌猴TNF-α的細(xì)胞 |
| 3520-4APW-2 | ELISpotPlus:人IL-17A(ALP) | 該ELISpot試劑盒用于通過ELISpot檢測方法技術(shù)分泌人IL-17A的細(xì)胞 |
| 3520-4HPW-2 | ELISpotPlus:人IL-17A(HRP) | 該ELISpot試劑盒用于通過ELISpot檢測方法技術(shù)分泌人IL-17A的細(xì)胞 |
| 3520M-4APW-2 | ELISpotPlus:猴IL-17A(ALP) | 該ELISpot試劑盒用于通過ELISpot檢測方法技術(shù)分泌猴IL-17A的細(xì)胞 |
| 3520M-4HPW-2 | ELISpotPlus:猴IL-17A(HRP) | 該ELISpot試劑盒用于通過ELISpot檢測方法技術(shù)分泌猴IL-17A的細(xì)胞 |
| 3521-4APW-2 | ELISpotPlus:小鼠IL-17A(ALP) | 該ELISpot試劑盒用于通過ELISpot檢測方法技術(shù)分泌小鼠IL-17A的細(xì)胞 |
| 3521-4HPW-2 | ELISpotPlus:小鼠IL-17A(HRP) | 該ELISpot試劑盒用于通過ELISpot檢測方法技術(shù)分泌小鼠IL-17A的細(xì)胞 |
| 3530-4APW-2 | ELISpotPlus:人IL-31(ALP) | 該ELISpot試劑盒用于通過ELISpot檢測方法技術(shù)分泌人IL-31的細(xì)胞 |
| 3530-4HPW-2 | ELISpotPlus:人IL-31(HRP) | 該ELISpot試劑盒用于通過ELISpot檢測方法技術(shù)分泌人IL-31的細(xì)胞 |
| 3540-4APW-2 | ELISpotPlus:人IL-21(ALP) | 該ELISpot試劑盒用于通過ELISpot檢測方法技術(shù)分泌人IL-21的細(xì)胞 |
| 3540-4HPW-2 | ELISpotPlus:人IL-21(HRP) | 該ELISpot試劑盒用于通過ELISpot檢測方法技術(shù)分泌人IL-21的細(xì)胞 |
| 3560-4APW-2 | ELISpotPlus:人IL-8(ALP) | 該ELISpot試劑盒用于通過ELISpot檢測方法技術(shù)分泌人IL-8(CXCL8)的細(xì)胞 |
| 3560-4HPW-2 | ELISpotPlus:人IL-8(HRP) | 該ELISpot試劑盒用于通過ELISpot檢測方法技術(shù)分泌人IL-8(CXCL8)的細(xì)胞 |

微信掃碼在線客服